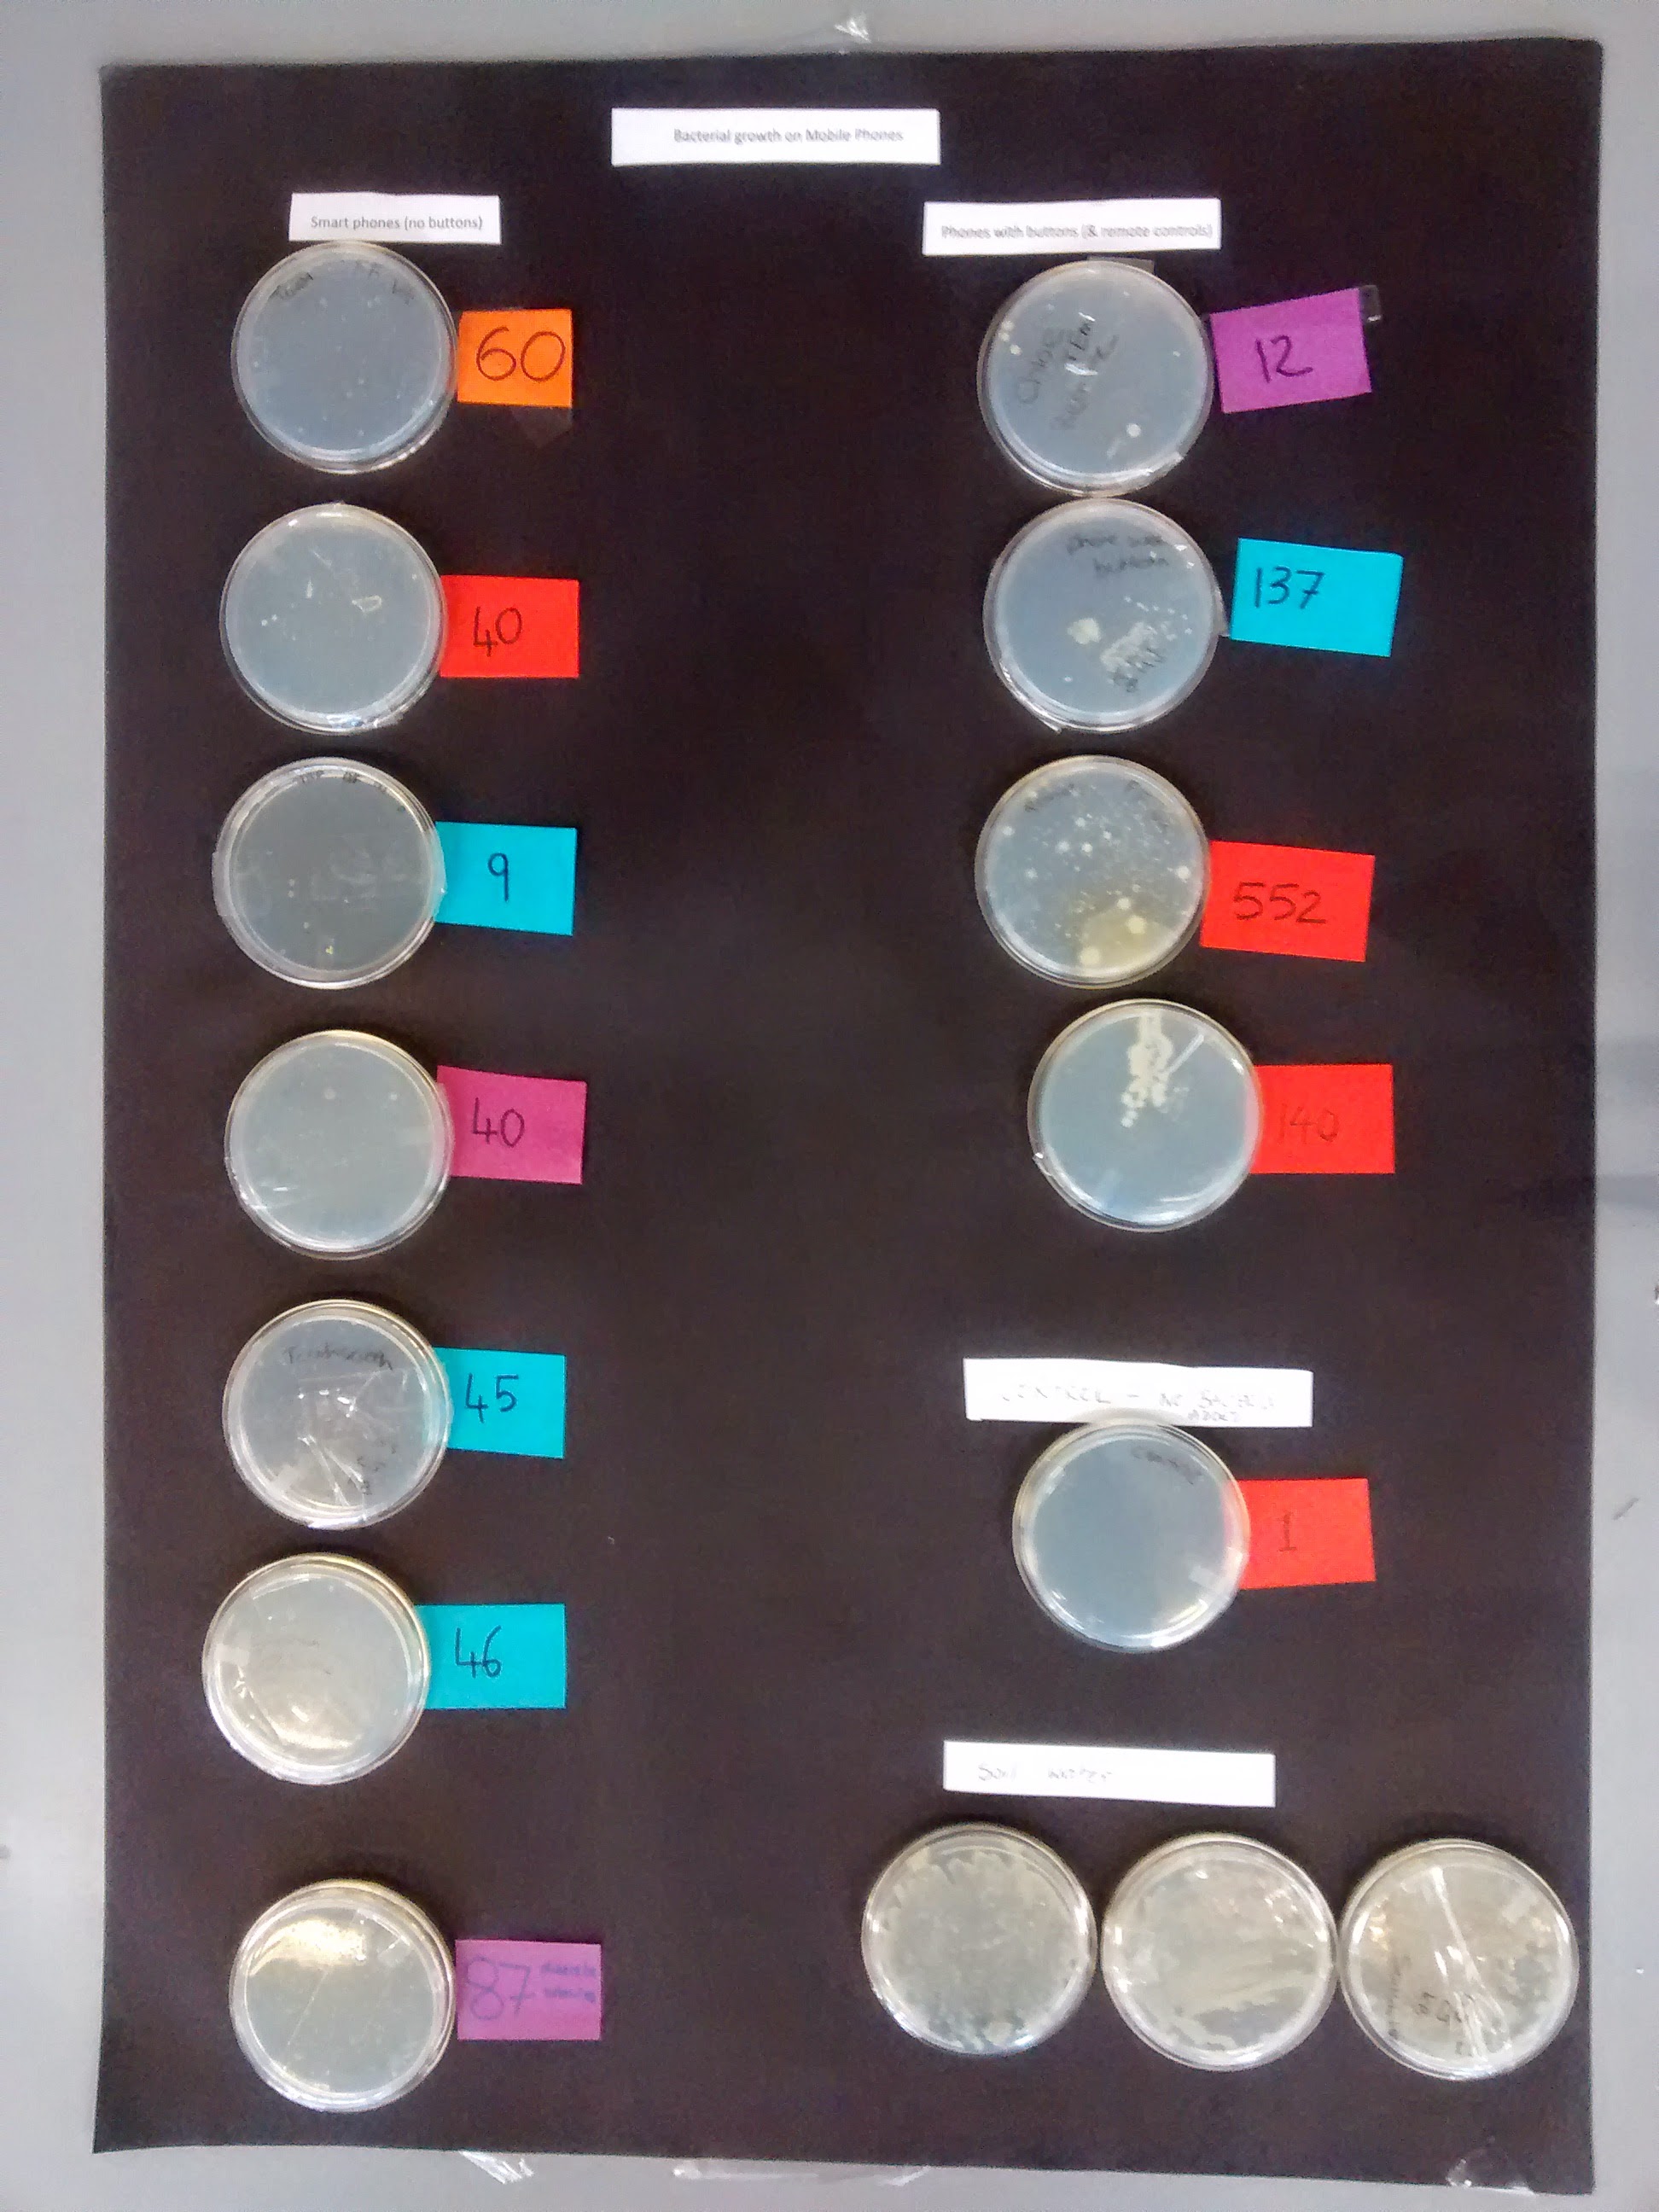
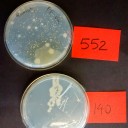
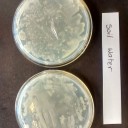
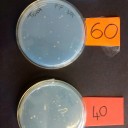
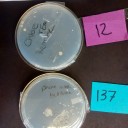

Mobile phone bacteria experiment
Are touch screen smartphones more hygienic than phones with buttons?
In a study in Austria 40 anesthetists working in an operating room were asked to use their personal in-hospital mobile phone for a short phone call. After use of the cell phone, bacterial contamination of the physicians' hands was found in 38 out of 40 cases.
In this experiment of prokaryotes students take samples from their mobiles phones and grow prokaryote colonies on agar plates. They investigate the hypothesis that mobiles phones harbour colonies of prokaryotes and that flatter touch screen smartphones are more hygienic than phones with buttons?
![]() The original study of anesthetists phones (in English)
The original study of anesthetists phones (in English)
Lesson Description
Guiding Questions
Do mobiles phones harbour colonies of prokaryotes?
Do phones with buttons harbour more bacteria than flat smartphones?
Activity 1: Experiment
Carry out the Experiment using the instructions on the ![]() Student worksheet - bacteria on mobile phones below. It is equally possible to compare computer keyboards with phones, or student calculators, if there aren't enough phones to test in the lab.
Student worksheet - bacteria on mobile phones below. It is equally possible to compare computer keyboards with phones, or student calculators, if there aren't enough phones to test in the lab.
Activity 2: Beware of internet prokaryotes - WebQuest
Complete the following exercise, ![]() Student worksheet - beware of internet prokaryotes, which covers prokaryote cell structure and function, and explores the accuracy of information found on the internet.
Student worksheet - beware of internet prokaryotes, which covers prokaryote cell structure and function, and explores the accuracy of information found on the internet.
Students unfamiliar with prokaryote structure may like to look at this lesson first Prokaryote cell structure & function or look at this site for a reminder ![]() Cells Alive prokaryote structure and function
Cells Alive prokaryote structure and function
Teachers notes
This experiment is likely to produce very variable results, but will hopefully show growth of bacteria in colonies on both types of phone. As mobile phones are more and more without buttons I have also tested the remote control for the TV, projector, the keyboard of a computer, or a student's watch.
If it's important to be sure that colonies grow, then put a few drops of soil water onto one or two Petri dishes as a 'sample'. Soil water is made by shaking some fresh soil in a small bottle of water and letting the water settle. Decant the grey solution into another sterile bottle. Many colonies will grow from this solution.
The experiment will only take 30 minutes to set up, so it can be usefully combined with work on prokaryote cell structure (Activity 2).
In the following lesson it will take 30 minutes to record the growth of colonies and then some time to write a conclusion, test the difference between the two means with a box plot, a t-test.
There are a number of ways to record the growth:
- count the discrete colonies on each Petri dish.
- estimate the surface area of the agar with bacterial growth
- describe the growth in a more qualitative way, using the descriptive words in the worksheet.
Here are some photos of results from this experiment in 2014. Click to enlarge them.
To see a large image of the class results click the eye icon:
Points for consideration
Some bacteria will grow faster than others, so measuring area covered by bacteria will overestimate fast growing species,
Uncertainties estimations are interesting in this experiment. It is not essential to give an uncertainty for a simple count, but if the numbers get large, asking the student, 'could that be 56 colonies not 50?', or could it be 51 colonies? usually gets them thinking in the right sort of way.
Extension work
Read the original scientific paper about this problem of hygiene in hospitals. Research the issue of mobile phones in operating theatres and try to find some other studies which investigate the same thing.

 IB Docs (2) Team
IB Docs (2) Team